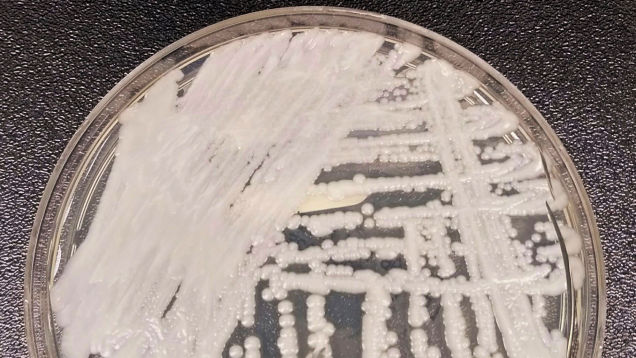

A frightening superbug yeast that’s killing people in hospitals can also survive just fine outside of them, according to a new study out Tuesday. For the first time, researchers say they’ve discovered multidrug-resistant strains of the fungus Candida auris in a natural environment, in the remote wetlands of India.…
Source: Gizmodo – Deadly Super Yeast Found in the Wild for the First Time